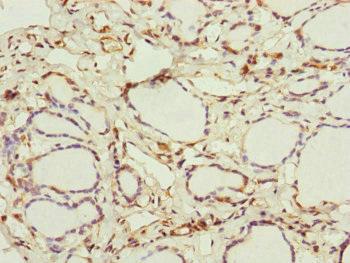

IFT20 Antibody
-
中文名稱:IFT20兔多克隆抗體
-
貨號:CSB-PA810295ESR2HU
-
規格:¥440
-
圖片:
-
其他:
產品詳情
-
產品名稱:Rabbit anti-Homo sapiens (Human) IFT20 Polyclonal antibody
-
Uniprot No.:
-
基因名:IFT20
-
別名:IFT20Intraflagellar transport protein 20 homolog antibody; hIFT20 antibody
-
宿主:Rabbit
-
反應種屬:Human
-
免疫原:Recombinant Human Intraflagellar transport protein 20 homolog protein (1-132AA)
-
免疫原種屬:Homo sapiens (Human)
-
標記方式:Non-conjugated
-
克隆類型:Polyclonal
-
抗體亞型:IgG
-
純化方式:Antigen Affinity Purified
-
濃度:It differs from different batches. Please contact us to confirm it.
-
保存緩沖液:PBS with 0.02% sodium azide, 50% glycerol, pH7.3.
-
產品提供形式:Liquid
-
應用范圍:ELISA, IHC
-
推薦稀釋比:
Application Recommended Dilution IHC 1:20-1:200 -
Protocols:
-
儲存條件:Upon receipt, store at -20°C or -80°C. Avoid repeated freeze.
-
貨期:Basically, we can dispatch the products out in 1-3 working days after receiving your orders. Delivery time maybe differs from different purchasing way or location, please kindly consult your local distributors for specific delivery time.
-
用途:For Research Use Only. Not for use in diagnostic or therapeutic procedures.
相關產品
靶點詳情
-
功能:Part of intraflagellar transport (IFT) particles involved in ciliary process assembly. May play a role in the trafficking of ciliary membrane proteins from the Golgi complex to the cilium. Regulates the platelet-derived growth factor receptor-alpha (PDGFRA) signaling pathway. Required for protein stability of E3 ubiquitin ligases CBL and CBLB that mediate ubiquitination and internalization of PDGFRA for proper feedback inhibition of PDGFRA signaling. Essential for male fertility. Plays an important role in spermatogenesis, particularly spermiogenesis, when germ cells form flagella. May play a role in the transport of flagellar proteins ODF2 and SPAG16 to build sperm flagella and in the removal of redundant sperm cytoplasm. Also involved in autophagy since it is required for trafficking of ATG16L and the expansion of the autophagic compartment.
-
基因功能參考文獻:
- intraflagellar transport protein 20 (IFT20) interacts with E3 ubiquitin ligases c-Cbl and Cbl-b and is required for Cbl-mediated ubiquitination and internalization of PDGFRalpha for feedback inhibition of receptor signaling. PMID: 29237719
- the traffic-related role of an IFT20 complex that includes components of the intracellular trafficking machinery in immune synapse assembly, is reported. PMID: 28154159
- IFT20 is required for the delivery of the intracellular pool of LAT to the immune synapse in naive primary T lymphocytes. PMID: 26715756
- Data report the molecular cloning and characterization of a novel human cDNA encoding a putative protein of 158 amino acid residues which shares high homology to Mus musculus intraflagellar transport protein mIFT20. PMID: 14672413
- This work suggests that IFT20 functions in the delivery of ciliary membrane proteins from the Golgi complex to the cilium. PMID: 16775004
顯示更多
收起更多
-
亞細胞定位:Golgi apparatus, cis-Golgi network. Cytoplasm, cytoskeleton, microtubule organizing center, centrosome, centriole. Cytoplasm, cytoskeleton, cilium basal body. Cell projection, cilium. Cytoplasm, cytoskeleton. Golgi apparatus.
-
組織特異性:Expressed in almost all tissues.
-
數據庫鏈接:
Most popular with customers
-
-
Phospho-YAP1 (S127) Recombinant Monoclonal Antibody
Applications: ELISA, WB, IHC
Species Reactivity: Human
-
-
-
-
-
-